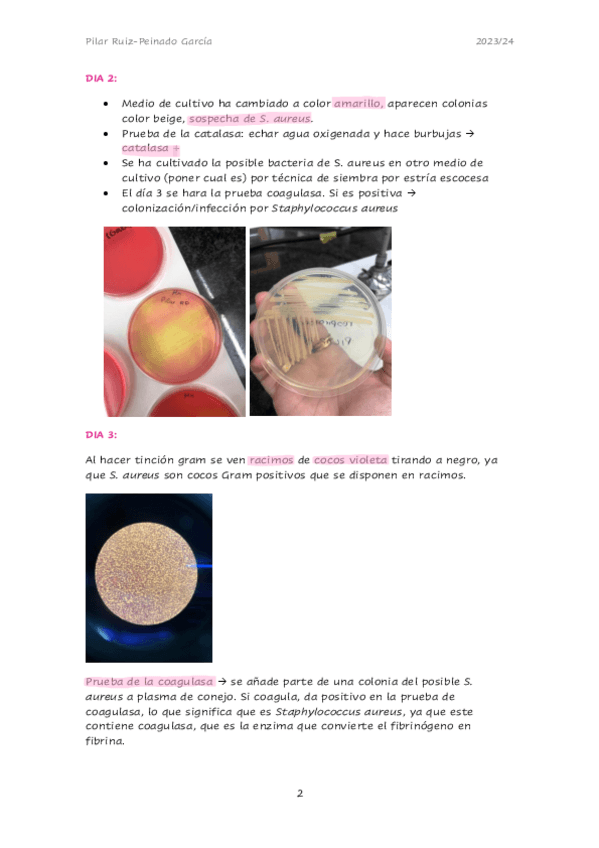

Microbiología y Parasitología Generales
apuntes
-
Apunts micro general horitzontal
Teniu un doc amb un enllaç que porta al meu drive, per si no ho podeu descarregar
He publicado nuevos examenes de 3º Microbiología y Parasitología Generales: recopilatori-micro.pages
He publicado nuevos examenes de 3º Microbiología y Parasitología Generales: recopilatori-micro.pages
Seminaris curs 25/26 - falta el seminari 8 (meningitis no el va donar i antibiograma no entra)
He publicado nuevos apuntes de 3º Microbiología y Parasitología Generales: Vacunes.pdf
He publicado nuevos apuntes de 3º Microbiología y Parasitología Generales: Resum-micosis.pdf
He publicado nuevos apuntes de 3º Microbiología y Parasitología Generales: Resum-taules-Helmints.pdf
He publicado nuevos practicas de 3º Microbiología y Parasitología Generales: Examen-Practicas-micro-lab-2025-26.pdf
He publicado nuevos apuntes de 3º Microbiología y Parasitología Generales: tablas-micro.pdf
He publicado nuevos apuntes de 3º Microbiología y Parasitología Generales: Parasitologia.-PROTOZOUS.pdf
He publicado nuevos apuntes de 3º Microbiología y Parasitología Generales: Fotos-muestras-micro.pdf
He publicado nuevos apuntes de 3º Microbiología y Parasitología Generales: Fotos-practica-examen.pdf
He publicado nuevos apuntes de 3º Microbiología y Parasitología Generales: PRACTICAS-MICROBIOLOGIA.pdf
He publicado nuevos apuntes de 3º Microbiología y Parasitología Generales: PRACTICAS-MICROBIOLOGIA-Y-PARASITOLOGIA-GENERALES.pdf
He publicado nuevos apuntes de 3º Microbiología y Parasitología Generales: PRACTICAS-MICRO.pdf
He publicado nuevos apuntes de 3º Microbiología y Parasitología Generales: Simulacro-Examen-Practico-Micro.pdf
He publicado nuevos apuntes de 3º Microbiología y Parasitología Generales: Simulacro-Examen-Practico-Micro.pdf
He publicado nuevos apuntes de 3º Microbiología y Parasitología Generales: Hongos-examen-practico.pdf
He publicado nuevos apuntes de 3º Microbiología y Parasitología Generales: Protozoos-examen-practico.pdf
He publicado nuevos apuntes de 3º Microbiología y Parasitología Generales: Helmintos-Examen-Practico-Micro-2.pdf
He publicado nuevos apuntes de 3º Microbiología y Parasitología Generales: REPASO-PROTOZOUS-LAB.pdf
He publicado nuevos apuntes de 3º Microbiología y Parasitología Generales: REPASO-HELMINTOS-LAB.pdf
He publicado nuevos apuntes de 3º Microbiología y Parasitología Generales: REPASO-HONGOS-LAB.pdf
He publicado nuevos apuntes de 3º Microbiología y Parasitología Generales: Fotos-Practiques-microbiologia-i-parasitologia-general.pdf
He publicado nuevos apuntes de 3º Microbiología y Parasitología Generales: Esquema-Practiques-Micro.pdf
He publicado nuevos apuntes de 3º Microbiología y Parasitología Generales: Apuntes-practicas-micro.pdf
He publicado nuevos apuntes de 3º Microbiología y Parasitología Generales: Practica-1-2-3-4.pdf
He publicado nuevos apuntes de 3º Microbiología y Parasitología Generales: Practicas-Cosas-Imp.pdf
He publicado nuevos apuntes de 3º Microbiología y Parasitología Generales: APUNTES-PRACTICAS-MICROBIOLOGIA-Y-PARASITOLOGIA-GENERALES.pdf
He publicado nuevos practicas de 3º Microbiología y Parasitología Generales: MICRO-PRACTIQUES-RESUM-TAULA.pdf
He publicado nuevos practicas de 3º Microbiología y Parasitología Generales: RESUM-SEMINARIS-PRACTIQUES.pdf
He publicado nuevos practicas de 3º Microbiología y Parasitología Generales: DEFINCIONS-EXAMEN-MICRO-PRACTIQUES.pdf
He publicado nuevos apuntes de 3º Microbiología y Parasitología Generales: GUION-PRACTICAS.pdf
He publicado nuevos apuntes de 3º Microbiología y Parasitología Generales: DESCRIPCIONS-EXAMEN-PRACTIC.docx.pdf
He publicado nuevos apuntes de 3º Microbiología y Parasitología Generales: MICRO-parasitos-tabla.pdf
He publicado nuevos apuntes de 3º Microbiología y Parasitología Generales: tema-7-8-genetica-microbiana.pdf
He publicado nuevos apuntes de 3º Microbiología y Parasitología Generales: Tema-14.-Antiseptics-i-Tema-15.-Vacunes.pdf
He publicado nuevos apuntes de 3º Microbiología y Parasitología Generales: TEMA-25-26-Micosis.pdf
He publicado nuevos apuntes de 3º Microbiología y Parasitología Generales: TEMA-24-micologia.pdf
He publicado nuevos apuntes de 3º Microbiología y Parasitología Generales: TEMA-23-artropodes-resums-micro.pdf
He publicado nuevos apuntes de 3º Microbiología y Parasitología Generales: TEMA-22-HELMINTS.pdf
He publicado nuevos apuntes de 3º Microbiología y Parasitología Generales: TEMA-22-NEMATODES.pdf
He publicado nuevos apuntes de 3º Microbiología y Parasitología Generales: Tema-19.-Parasitologia-Generalitats.pdf
He publicado nuevos apuntes de 3º Microbiología y Parasitología Generales: TEMA-20.1-Protozous-intestinals-i-urogenitals.pdf
He publicado nuevos apuntes de 3º Microbiología y Parasitología Generales: TEMA-20.2-Protozous-parasits-de-sang-i-teixits.pdf
He publicado nuevos apuntes de 3º Microbiología y Parasitología Generales: Tema-16.-Taxonomia-e-identificacion-bacterianaa.pdf
He publicado nuevos apuntes de 3º Microbiología y Parasitología Generales: TEMA-15.-vacunes.pdf
He publicado nuevos apuntes de 3º Microbiología y Parasitología Generales: Tema-14.-Antiseptics.pdf
He publicado nuevos apuntes de 3º Microbiología y Parasitología Generales: TEMA-9-micro-general-resums.pdf
He publicado nuevos apuntes de 3º Microbiología y Parasitología Generales: tema-7--PCR.pdf
He publicado nuevos apuntes de 3º Microbiología y Parasitología Generales: TEMA-8-OMIQUES.pdf
He publicado nuevos apuntes de 3º Microbiología y Parasitología Generales: TEMA-5-ESTRUCTURA-VIRUS.pdf
He publicado nuevos apuntes de 3º Microbiología y Parasitología Generales: TEMA-2-I-3-estructura-i-funciona-bacteriana.pdf
He publicado nuevos apuntes de 3º Microbiología y Parasitología Generales: TEMA-6-metabolisme-microbia.pdf
He publicado nuevos apuntes de 3º Microbiología y Parasitología Generales: MICRO-RESUM-TOT.pdf
He publicado nuevos apuntes de 3º Microbiología y Parasitología Generales: TEMA-1-evolució-i-historia.pdf
He publicado nuevos apuntes de 3º Microbiología y Parasitología Generales: T-6-Esquemas-Nutricion.pdf
He publicado nuevos apuntes de 3º Microbiología y Parasitología Generales: PREGUNTAS-EXAMENES-SEMINARIS.pdf
He publicado nuevos apuntes de 3º Microbiología y Parasitología Generales: RESUM-SEMINARIS-MICRO.pdf